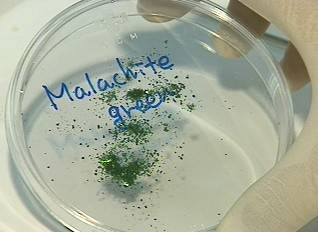
▲ 살균제나 염색제 등 산업용 염료로만 쓰리는 말라카이트 그린ⓒ뉴데일리 DB

메기 전량 폐기...172곳 전수 조사중
-

- ▲ 양식중인 민물메기ⓒ뉴데일리 DB
민물메기를 기르는 양식장에서 인체에 유해한 것으로 알려진 '말라카이트 그린'이 발견돼 전량 폐기됐다.
해양수산부와 식품의약품안전처는 29일 민물메기 양식장 42곳을 조사한 결과 5곳에서 미량(0.0047〜0.021㎎/㎏)의 말라카이트 그린이 검출됐다고 밝혔다.
말라카이트 그린은 밝은 청록색의 합성 염료로 과거 양식 어류에 기생하는 물곰팡이를 제거하기 위해 사용됐으나 인체에 유해한 것으로 알려진 뒤 식품에 사용하는 것이 금지된 물질로 살균제나 염색제 등 산업용 염료로만 쓰이고 있다.
-
- ▲ 살균제나 염색제 등 산업용 염료로만 쓰리는 말라카이트 그린ⓒ뉴데일리 DB
해당 업소에서 출하된 민물메기 중 현재 시중에 유통되고 있는 물량은 없는 것으로 조사됐다.
이번 검사 결과에 따라 해수부와 식약처는 국내에서 양식·유통되는 민물 메기의 안전성을 확보하기 위해 특별 조사를 실시하고 있다.
해수부는 전국 172개 메기 양식장 중 이미 조사를 마친 42곳을 제외한 130곳에 대해 전수 조사를 실시해 문제가 없는 것으로 확인된 양식장에 한해서만 신규 출하를 허용하기로 했다.
이와 별도로 식약처는 현재 시중에 유통 중인 국내 양식 민물메기에 대해 28일부터 특별 수거검사를 벌이고 있으며 유해물질이 검출되면 전량·판매 금지 조치할 방침이다.
말라카이트 그린이 검출된 양식장은 관련법규에 따라 징역 또는 벌금형 처분이 내려지고 6개월 동안 특별관리 대상으로 지정돼 관리된다.







